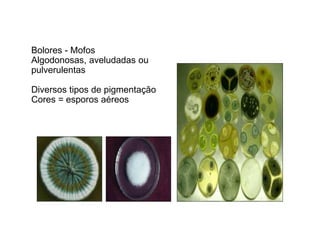
Bolores - Mofos 
Algodonosas, aveludadas ou 
pulverulentas 
Diversos tipos de pigmentação 
Cores = esporos aéreos

Os fungos possuem membrana celular com ergosterol, citosol com organelas como mitocôndrias e retículo endoplasmático, DNA associado a histonas. A parede celular contém quitina, glicanas e mananas. Reproduzem-se assexuadamente por brotamento e sexualmente por plasmogamia, cariogamia e meiose.